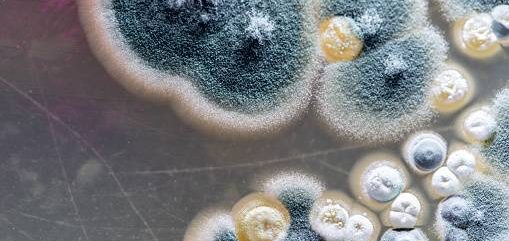

Trusted Leaders in Building Inspection and Energy Compliance
Founded to meet growing demand for thorough building inspections and energy assessments, Construction Inspection Specialists has established a reputation for excellence. We are committed to providing accurate, reliable, and comprehensive services that help property owners and developers maintain healthy, energy-efficient buildings that meet all regulatory standards.
Meet Our Expert Team
Our team of qualified inspectors and assessors bring years of experience and updated knowledge on building regulations, using the latest technology to deliver insightful reports and practical recommendations tailored to your property needs.
